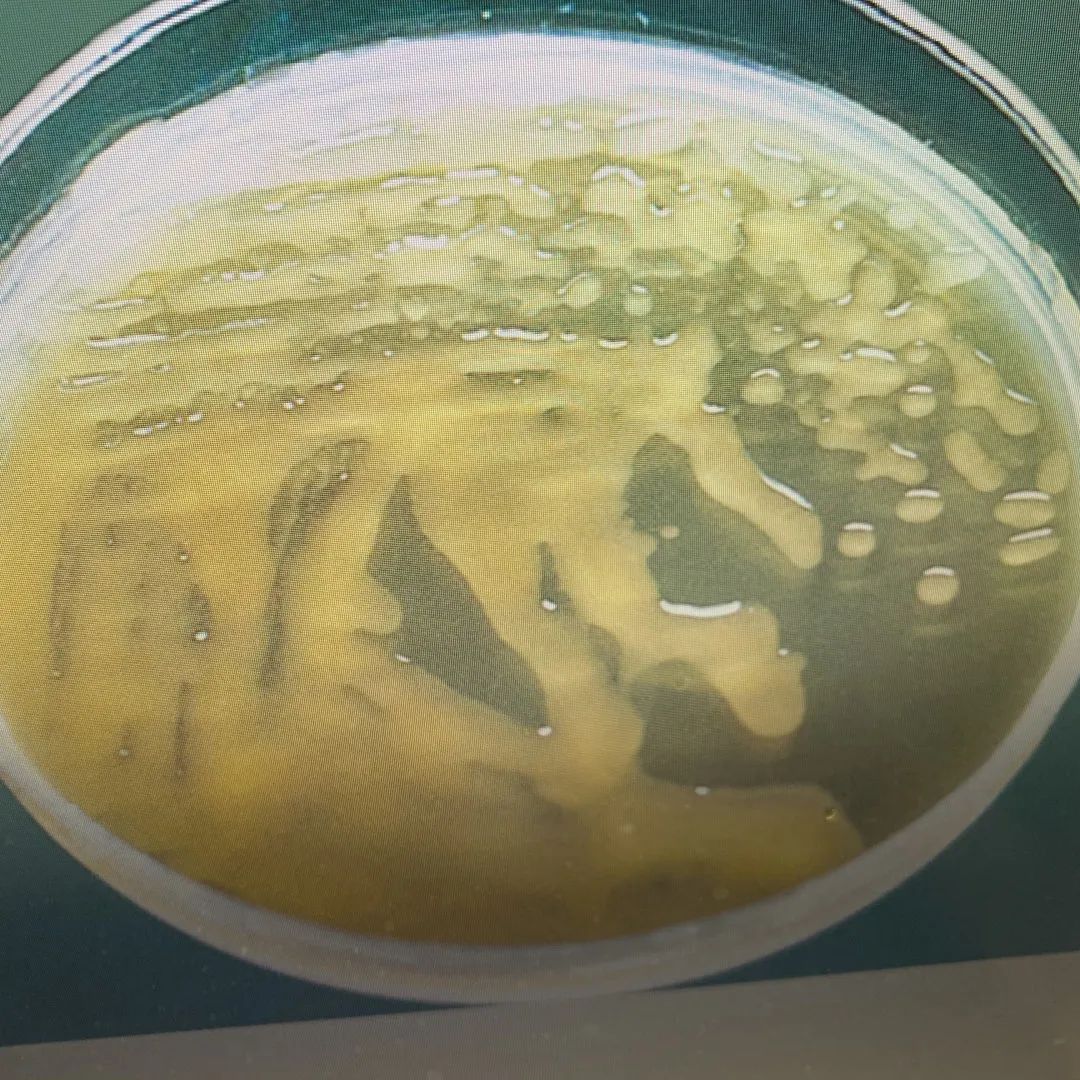

周庭银|一位老兵的微生物传奇之旅
原创 龚芷葳 晔问仁医
 周庭银
周庭银开启微观世界的大门
人物介绍
 周庭银:海军军医大学长征医院检验科主任技师。
周庭银:海军军医大学长征医院检验科主任技师。从事临床微生物检验及科研工作40余年,在临床微生物鉴定方面积累了丰富的经验,尤其是对疑难菌、少见菌株鉴定的研究有独到之处。
在国内首次发现卫星状链球菌、星座链球菌、霍氏格里蒙菌、拟态弧菌等多株新菌株。近年来先后帮助国内多家医院鉴定40余株疑难菌株。主办国家继续医学教育“疑难菌株分离与鉴定”学习班25期(培训3500余人),2013年发起成立上海疑难菌读片会,并成功举办15期。
针对血培养瓶内有细菌生长,但革兰染色看不见细菌,转种任何平板无细菌生长这一难题,研究出解决的办法——瑞氏染色,有助于及时发现有无细菌,确保血培养一级报告的准确性。研制了新型双相显色血培养瓶、多功能体液显色培养瓶、尿培养快速培养基、抗酸杆菌消化液、以及一种既适用于痰标本细菌培养,又适用于结核分枝杆菌和抗酸杆菌涂片的液化留置容器。获国家实用新型专利5项、发明专利1项。第一主编临床微生物学专著13部,其中《临床微生物学诊断与图解》获华东地区优秀科技图书一等奖。总主编12部,《医学实验室ISO15189认可指导丛书》第一版、第二版,参编著作3部,以第一作者发表论文40余篇。
第一视角
周庭银
“在微生物的世界里驰骋,是我最开心的事情。开启这个微观世界,我发现了无数令人惊叹的奇迹,也解锁了一个又一个的生命密码。”海军军医大学长征医院检验科主任技师周庭银向我们诉说着微生物人的骄傲和传奇。
军魂不改,岁月如金。
他在上海长征医院检验科工作了51年,从士兵成长为文职大校,在微生物领域深耕40余年,创造了一个又一个第一。业界称他有三 “多”:一是著作多,第一主编著作13部,书本内容涵盖了临床微生物基础理论、临床关注的血流感染、胃肠道感染和医学实验室质量管理体系等内容,涵盖面多深广全;二是发明多,针对无菌体液阳性率低,标本采集后不能及时接种影响细菌的检出率,他发明的“香水瓶”——双相体液培养瓶,采用固液相结合的原理,接种快捷方便。三是点子多,他首先采用“移花接木”的方式研究并解决了血培养瓶内有细菌生长,但革兰染色看不见菌,不能及时给临床发出准确的一级报告这一难题,他研究发现用瑞氏染色查见细菌,确保一级报告的准确性;血培养报阳涂片有细菌,转种任何平板无细菌生长,他研究出用血培养瓶培养液制成平板,使细菌成功生长等方法,提高临床血培养阳性检出率;布鲁菌血液培养一般需要4~5天报告临床,报告时间长影响临床诊断及治疗,他研究指出,若血培养报阳涂片革兰染色疑似布鲁菌,他能1~2h鉴定出布鲁菌,为临床更快的提供准确报告;他研究发现需氧血培养瓶内可以分离出有些厌氧菌,比如脆弱拟杆菌、第三梭菌等。当时很多医院不能开展厌氧血培养,因厌氧菌血平板用量少,购置困难,他研究出用普通血平板代替,解决了难题。尿路感染病人,尿常规白细胞多临床疑似感染,但培养多次无细菌生长,他认为尿液标本有白细胞,肯定有病原菌,通过研究他找到可以培养出病原菌的方法,给临床提供准确的诊断和敏感的药物,使病人得到及时治疗;铜绿假单胞菌黏液型菌落做生化反应全部阴性,药敏平板不生长,他研究出方法可以使细菌生长,为临床提供正确报告;痰培养一直用接种环挑取标本,但病原菌阳性检出率低,他研究出用棉签涂布第一区,再用接种环划线,大大提高病原菌阳性检出率;尿液标本涂片找抗酸杆菌,阳性率低,他研究发现尿离心沉淀涂片脱落的原因,他用接种环蘸取血清再涂片保证不脱落,提高了抗酸杆菌阳性检出率等等。他为临床微生物检验中解决很多大家困惑的问题。
他创立了15个微信群7000余人,一个微生物公众平台(临床微生物论坛,是临床微生物检验领域国内影响较大的公益性交流平台),其中公共平台已有22000余人,涉及32个省市(包括港澳台),300多个大小城市。他成功举办25期学习班3500余人,传授临床微生物最新进展和临床经验,深受全国临床微生物专家和同行的认可和好评。
面对这一个个挑战,他说,生命本来就是一场奔波,一路地波折,不停地跨越,一路地艰辛,不断地超越,一路上成长着、感恩着。生活像杯美酒,需要慢慢来品尝,初尝会感觉到辛辣苦涩,细品之后便会觉得回味无穷。
 1、从医之路
1、从医之路至今,他还记得光荣入伍的那年——1970年12月。这是中国的转折点,也是他光辉人生的起点。
作为一名士兵,他扛起了巨大的责任,背负着荣誉、勇气和信念。每天五点钟在晨光尚未照耀大地的清晨,他早早起床,穿上厚重的军装,开始一日艰苦的训练。有时冒着严寒的冬日,有时承受着炙热的酷暑,在这里他养成了坚韧的品格。他明白,只有通过不断地锻炼才能成为一名真正的战士。在他的字典中,没有退缩、抱怨、放弃,只有坚韧、毅力、奋斗。他的身上闪耀着不屈,是国家的脊梁,是人民的守护者。士兵的苦,历尽艰辛,尽在他们的坚毅目光与铮铮声色之中。
1972年5月,他因表现出色,被送往被送往第二军医大学第二附属二院(西安霸桥二院)护训队培训,从此走上了他的从医之路。经过六个月的集训,他被分配到第二军医大学附属第二医院检验科轮转。后来,他又刻苦学习考上第二军医大学成人夜校大专医疗技术专业。三年后,他又考上第三军医大学函授医学检验本科。
当时,检验科设有生化组、临床检验组和微生物组等 3个专业。他在完成轮转后,发现自己最喜欢微生物组。然而,由于检验科人手有限,他不能仅专注于临床微生物学专业的研究,而选择了参与全科轮转检验工作。
在这昏暗的实验室中,灯光投射出微弱的光芒,映衬着微生物人专注而坚定的面容。他仔细分析每一个样本,描绘出患者的健康画像。无论是血液、尿液还是组织标本,他们将其置于平板上,耐心等待结果的呈现。
渐渐地,他对临床微生物检验的专业使命产生了更深刻的理解。他深知病原体和疾病之间的关联密切,因此他认为只有找到病原体才能找到治疗方法的捷径,这不仅让他对自己的职业有了更深的认识,也让他意识到微生物研究是自己的未来,也能为患者作出无可替代的贡献,因为这是很多疾病治疗的寻根之路。
1985年,他开始专职临床微生物检验和研究工作。他深感这是一项具有非常重要意义的工作,在他的心中,每一种微生物都蕴含着无限的奥秘和可能性。在工作中,遇到少见菌、疑难菌,他都进行拍照与保存资料。
“在70年代,我梦想出一本临床微生物学专业的书,当时科主任觉得这个想法太过雄心勃勃并难以实现。的确是那时候条件差,没有电脑,书和资料都很稀有,很多资料都是手抄的。但我坚信自己一定会实现,只要自己做好长远准备,在平时工作中遇到疑难菌、少见菌进行研究并收集实验资料和临床资料,抓紧基础理论知识的学习和临床实践经验的积累,就一定能够实现这个梦想。”
从此,他与他的微生物室融为一体,终年无休。工作看起来很安静,但实际上他的工作充满了活力和激情。他始终关注着每一个疑难细菌,关注相关的样本,始终将患者放在心中最重要的位置上,始终坚持钻研。每当面对疑难细菌或复杂的样本,他从不退却,反而更加坚定地投入钻研中。他阅读国内外最新的研究资料,与同行们交流讨论,不断挑战自己的智慧和能力。他明白,只有持续地学习和进步,才能够为患者提供、及时准确的报告。
“至今,我还记得老一代检验人马子行老师对我说, 检验工作一定要刻苦钻研,学好英语,会做会写善于结,才能做名人。” 也正是马子行老师的一番话,给予了他更多的信念和勇气,也让他看到了自己追求梦想的灯塔。
他常说:“别人不会做的你会做,别人发现不了的你可以发现,别人不会写的你会写,碰到疑难细菌切忌模棱两可报告,要去研究它。”曾经有一案例,黄XX,男,74岁,于2013年4月中旬出现咳嗽,咳痰,为大量白色黏液样痰,每日约100ml。5月20日至浙江XX大医院就诊,胸部CT示“两肺气肿伴感染,左肺及右中肺间质性病变“,WBC10.6*10^9/L,N% 80.6%”,诊断“间质性肺炎”。予“舒普深”抗感染,“甲强龙连用5天”后改为“甲泼尼龙”抗炎治疗,症状好转后于6月6日出院,出院后“甲泼尼龙片”抗炎,不见效果。7月4日就诊于长征医院呼吸科,白色黏液样痰,以“左上肺阴影待查”收入院。多次痰培养未检出致病菌,但临床高度怀疑感染,打电话给他协助他们诊断,次日下午,他在涂片染色中发现肿瘤细胞,最后诊断为腺癌。
痰培养规范要求在培养前必须涂片镜检,为此患者历经两个医院检查治疗,送了多个痰标本,经过多个检验人员涂片,没有发现肿瘤细胞,导致误诊,值得大家深思,微生物检验人员必须干一行、爱一行、钻一行、提高自身水平。
对他而言,前进不仅是一种鞭策和动力,更是一种使命感。他知道,要研究各种细菌的特征和生命方式,就要精通各种检测方法和实验技术,遇到问题能够自主解决。在这基础上,还需要把自己的研究成果被更广泛地接受和认可,集思广益,才能走得更好,走得更远。他努力学习英语,提高自己的英文论文阅读和写作能力,在微生物界中走得更加宽广。
不忘初心




 ✓
✓探索微观世界的奇妙之旅


 点击看大图
点击看大图 2、成果斐然,寓教于乐
2、成果斐然,寓教于乐“我最欣慰的是能够得到大家的信任,有时外省市医院鉴定不出来的疑难菌,送到我院鉴定,最终鉴出来。他们为了感谢我,邀请我吃饭。但我认为吃饭不重要,重要的是我帮他们鉴定出疑难菌,我留下宝贵资料和照片,这是我最大的快乐!”
随着工作的积累和提高,他逐渐成为中国临床细菌检验领域的传奇人物之一。他曾在国内率先发现了卫星状链球菌、星座链球菌、霍氏格里蒙菌、拟态弧菌等多株新菌株,这些重要的发现奠定了他在临床微生物领域的专业水平和卓越贡献。
“以前医院条件很差,发现新菌株并不容易,但我真的很喜欢挑战。有时候甚至都忘记了吃饭,只要研究出来我就很开心。”
当时的实验条件简陋,设备落后,工作环境也很艰苦,但他富有激情,他勤奋努力,一心一意地投入到微生物检验中。对于他来说,把自己融入到微生物研究中是最快乐的事情之一。
在他的工作中,“精准性”塑造了他的研究人生,他不断地探索、创新和实践,一次又一次地超越自我,最终获得了丰硕的成果。他的坚持和努力也得到了回报,他的成就被大家所认可和肯定,他的工作为人们的健康保驾护航。
不仅如此,他还于2013年发起成立上海疑难菌读片会,并成功举办了15期会议。这一会议为年轻医生和同行提供了一个互相交流学习的平台,让更多的人受益于他的专业知识和经验。他的读片会有一个特点——专注和严谨,他的精彩讲解吸引了众多参会者的目光。参会者们认真地听着他的分享,他们热情而又投入地参与到这个学术交流平台中。他的讲解通俗易懂。他不仅凭借丰富的经验和知识,还用自己的生动案例来解答听众的问题。
“在这里,每个人都有所收获。”这样的活动不仅为行业和年轻人提供了优秀的学习交流平台,也展示了他的学术精神和格局,为细菌相关研究的医学教育事业作出表率。
培训和教育是为了授人以渔。在他看来,这样的教育和培训做得好,可以救治很多人的生命。他说,如果报告不及时,病人就会错过治疗时机。如果报告错误,就会滥用抗生素,产生超级耐药菌,无论哪种情况都是不能被接受的。例如,有一位病人在上海某大医院住院,发烧症状明显,但白细胞低,多次血培养也没有查出病原菌,医生将其诊断为伤寒,治疗一个月后出院。两个星期后这位病人的疾病复发,来到长征医院就诊。当时抽了血培养,24h血培养阳性报警,革兰染色未见到细菌,后来我了解病人病情,确定病人肯定感染,重新取培养物涂片,用我的方法——瑞氏染色,查到病原菌,最后正确鉴定为马尔他布鲁菌,医生对症用多西环素和利福平治疗,病人很快退烧,四星期后病人治愈,再无复发。
他从一名士兵起步,他的临床微生物学生涯充满了传奇色彩,他并非科班出身,却凭借对微生物的热爱和坚韧不拔的毅力,始终不懈地学习,最终成为中国最知名的临床微生物专家,默默地推动着我国临床微生物检验事业的发展。
他觉得,虽然现今科技日新月异,但细菌培养等基础检验能力仍不可或缺。“尽管现在有了先进的测序技术,但在临床应用上仍需等待,我们急需培养一批基础扎实的微生物检验人才,这正是我致力于培训工作的原因。虽然基因测序技术有很多优势,但其成本较高,且不能直接用于药物敏感试验。相比之下,临床上的血培养成本较低,且可以直接用培养出的细菌进行药物敏感试验,为临床医生提供诊断和治疗的依据。”



 点击看大图
点击看大图 3、微生物界的“发明家”
3、微生物界的“发明家”在血培养瓶中报阳的情况下,他发现有些细菌即使存在,用革兰染色方法也无法观察到。这些细菌甚至在任何平板上都无法生长。于是,他经过深入研究,成功地将瑞氏染色技术引入实验中,使细菌在显微镜下更加清晰可见。这一创新为临床诊断和治疗提供了更加可靠的依据。他初次面对这个困惑时,并未轻言放弃。经过反复思考和实验,他决定尝试运用瑞氏染色技术来解决这个问题。这种方法起初广泛应用于细胞学领域,用于检测细胞形态结构。
作为一名临床微生物专家,他一直重视临床工作的研究,致力于提高实验室的技术能力和创新能力。除了传统检验方法,他一直努力寻找新的方法和工具来解决临床上的问题。他研制了双相显色血培养瓶、多功能体液显色培养瓶、尿培养快速培养基等,这些方法不仅提高了实验室效率,也提升了检验科的技术水平。
另外,他还研制了一种抗酸杆菌消化液,这种消化液不仅具有强大的抗菌能力,还能够加快样本处理的速度,为快速诊断疾病提供更可靠的保障。对于临床检验,抗酸杆菌消化液具有较高的诊断价值和准确性。它不仅可以有效地缩短检测时间,还可以提高检测效率和准确性,减少误检率和漏检率。
同时,他也提出了一种既适用于痰细菌培养又适用于结核分枝杆菌和抗酸杆菌培养的痰标本液化留置容器,这种容器方便了实验操作,提高了样本的采集和保存效率,同时也减少了操作人员交叉感染的风险。
这些微小的创新发明都被广泛应用于临床治疗中,对行业的发展产生了深远的影响。他深信,只有通过持续的创新和改进创新,才能更好地服务于患者,推动检验医学事业的进步。因此,他获得了 5 项国家实用新型专利和 1 项发明专利。








 4、撰写专著,引领潮流
4、撰写专著,引领潮流他以第一主编的身份完成了13部临床微生物学专著,这些书籍已成为全国微生物检验领域的工具书和参考书。
由于他在临床微生物学领域有着非常丰富的经验和精湛的技艺,他觉得出版质量更高的临床微生物学专著是能造福检验界的。
近年来,医学微生物学检验发展很快,出现了许多新的检验方法和技术,包括半自动和全自动微生物鉴定系统等,但微生物的鉴定和分类仍然离不开传统的手工鉴定方法。形态学检查是细菌学和真菌学检验的主要手段之一。
自2001年起,国内外出版的有关医学微生物学和微生物检验方面的书籍很多,但用图谱(包括照片和示意图)直观地介绍医学微生物形态学及检验操作技术的书籍国内尚未查见此类书籍,《临床微生物学诊断与图解》填补了当时国内的空白,也获得了华东地区优秀图书一等奖。
周庭银作为第一主编,分别在 2005 年、2012 年和 2017 年出版了《临床微生物学诊断与图解》的第二版、第三版和第四版。这本书全面系统地阐述了临床微生物学诊断的知识和技术。第四版共包括八篇、40 余章,内容涉及细菌和真菌的形态与结构、微生物培养、染色、鉴别、临床标本采集与处理、抗菌药物敏感性试验和耐药性检测等技术,以及常见微生物的形态和鉴定方法等。书中附有超过 2500 幅彩色图片,深受我国临床微生物实验室检验人员、感染控制技术人员以及医学院校微生物检验专业师生的喜爱。该书被誉为临床微生物室的必备工具书和参考书,对于提高临床微生物学诊断能力和推动微生物学在医疗领域的应用发挥了积极作用。
2019年,他将精力投入医学实验室ISO15189认可指导丛书,他担任总主编,整本书邀请了全国一百多名微生物检验专家和认证专家参与编写;包括《临床微生物检验标准化操作程序》、《分子诊断标准化操作程序》、《医学实验室质量管理体系临床化学检验标准化操作程序》、《临床免疫检验标准化操作程序》和《临床血液和体液检验标准化操作程序》等内容。
随着国内越来越多医学实验室以申请ISO 15189实验室认可为契机,推动和促进医学实验室规范化管理水平、提高检验结果准确性和有效性。获得ISO15189认可是证实医学实验室质量和能力被国内外相关机构认可和结果互通互认的基础。ISO 15189:2022版医学实验室认可准则实施在即,为此,2023年1月,他又组织国内一百余名微生物检验专家多次对《CNASCL02:2023医学实验室质量和能力认可准则》学习理解,策划编写《医学实验室ISO15189认可指导丛书》第二版。
他希望新版本的丛书能够为各个实验室开展和运行ISO 15189认可提供积极的作用。该套丛书将提供详细的指导和规范,帮助实验室建立起高标准的质量管理体系。其中包括设定质量目标、建立质量控制措施、培训人员、进行内部和外部质量评估以及持续改进等方面的内容。通过阅读这一套丛书,实验室可以更好地理解ISO 15189标准的要求,并根据自身情况进行适当的调整和实施。
凭借着执着追求和坚定信仰,他为微生物学奉献了一生。他从青年时期开始步入医学的殿堂,坚信着在临床微生物学领域努力工作将会收获丰硕的成果。如今,退休后仍然率领着团队,为广大患者的健康贡献一份力量。他像一部精彩的文学作品,记录着他的职业生涯和人生追求,记录着以人民健康为己任,用行动去诠释自己的价值观和人生理念。
周庭银以第一主编的身份完成了
13部临床微生物学专著



 砥砺奋进
砥砺奋进
在每份检验样本中探微索隐,追寻蛛丝马迹,
在每份检验样本中探微索隐,追寻蛛丝马迹,为患者、为医生提供诊断和治疗的依据
 周庭银担任总主编完成了
周庭银担任总主编完成了12部临床微生物学专著





 / 口述实录 /
/ 口述实录 / Q
QA
晔问仁医

 周庭银
周庭银 晔问仁医
晔问仁医血液感染是重症患者的主要死亡原因之一,早期快速诊断并及时治疗对患者的预后至关重要,而血培养是目前诊断血液感染的金标准。临床上,为何血培养的检测阳性率会偏低?
周庭银
 血培养是诊断细菌血症和真菌血症的金标准;血培养为抗生素选择提供依据;发热患者中有13%左右 血培养阳性,实际只有5~8%。血培养作为临床上病原学诊断的重要方法之一,其阳性结果对于菌血症的明确诊断、对症治疗有极高的应用价值。
血培养是诊断细菌血症和真菌血症的金标准;血培养为抗生素选择提供依据;发热患者中有13%左右 血培养阳性,实际只有5~8%。血培养作为临床上病原学诊断的重要方法之一,其阳性结果对于菌血症的明确诊断、对症治疗有极高的应用价值。血培养的检测阳性率偏低的原因,40%是由于临床采血时机不掌握和采血前使用抗生素造成的,60%是微生物检验人员基础水平差,不能识别血培养中常见细菌的异常形态、复数菌漏检、不做厌氧瓶,需氧瓶报阳不转巧克力平板、血培养瓶报阳涂片查见革兰阳性球菌或革兰阴性杆菌,转种任何平板不生长后不去研究等十余种原因造成。
使得临床微生物检验质量受到很大影响,从而直接影响感染性疾病的有效治疗。,因此需要加强临床微生物检验人员基础操作的培训。
 晔问仁医
晔问仁医针对血培养瓶内有细菌生长,但革兰染色看不到细菌,转种任何平板无细菌生长这一难题,您研究出解决的办法——瑞氏染色,这样很清楚地发现有无细菌,确保血培养一级报告的准确性。您能详细介绍一下这种方法吗?
周庭银
 临床上,检验人员常会遇到这样的情况:血培养报阳后,涂片,镜下找不到细菌。这是因为革兰染色能分辨出革兰阴性和革兰阳性菌,但也有一个缺点,就是背景特别杂。有时候染的淡一些时,如果看片人员没有经验,就会漏掉。后来我改用瑞氏染色,用来辨别细菌,能极大的减少背景的干扰,让细菌更容易被我们找到。
临床上,检验人员常会遇到这样的情况:血培养报阳后,涂片,镜下找不到细菌。这是因为革兰染色能分辨出革兰阴性和革兰阳性菌,但也有一个缺点,就是背景特别杂。有时候染的淡一些时,如果看片人员没有经验,就会漏掉。后来我改用瑞氏染色,用来辨别细菌,能极大的减少背景的干扰,让细菌更容易被我们找到。 晔问仁医
晔问仁医您主办25期国家医学继续教育“疑难菌株分离与鉴定”学习班,为什么能连续火爆了25年?
周庭银
 我时常在想,如何把研讨会办得更有特色,更有水平,我总结为十七个字“领导支持,内容创新,结合临床,以学员为本。”
我时常在想,如何把研讨会办得更有特色,更有水平,我总结为十七个字“领导支持,内容创新,结合临床,以学员为本。”领导支持:学习班坚持到今天是在医院领导和历届检验科主任、在科室同事、微生物室人员的共同努力下,以及上海市内外各兄弟医院的鼎力支持下才一步步成长起来的。
内容创新:每次我们的研讨会都力求内容更新,不断推出新的专题。尤其是临床微生物学不断发展变化。新的菌株,新的耐药机制的出现鞭策着所有临床微生物检验人员不断更新知识,寻找应对之策,也加速了这一学科的发展,疑难菌的分离培养、多重耐药菌医院感染控制、CLSI手册更新内容等等。这些内容都在研讨会中有所体现。
结合临床:研讨会本着“从临床中来,到临床中去”的原则,每次的选题内容都是从临床微生物的常规工作中发现,并经过反复研究和实践总结出的经验。譬如,大家熟悉的由我主编的《临床微生物学诊断与图解》一书,是编者从事临床微生物检验几十年的经验和心得体会,并结合国内外最新的进展编著而成,得到了大家的认可。《临床微生物学诊断与图解》一书,是编者从事临床微生物检验几十年的经验和心得体会,并结合国内外最新的进展编著而成,得到了大家的认可。
以学员为本:这是研讨会发展到今天最重要的法宝。研讨会中探讨的问题,都是在征求了同行们的意见及提出的问题进行讲座。在研讨会期间遇到的各种问题,都将尽力为大家解决,让大家“来得开心,走得满意”。
 晔问仁医
晔问仁医《医学实验室ISO15189认可指导丛书》在实践中发挥了哪些作用?
周庭银
 本套丛书充分遵循准则的原则和要求,更是在实际操作层面给予读者提示和指引,旨在帮助医学实验室管理人员提高质量管理能力,为各医学实验室质量管理体系的建立提供参考,对拟申请ISO 15189认可的医学实验室具有一定的指导意义和实用价值,可作为医学实验室规范化管理和标准化操作的实用性工具书和参考书。
本套丛书充分遵循准则的原则和要求,更是在实际操作层面给予读者提示和指引,旨在帮助医学实验室管理人员提高质量管理能力,为各医学实验室质量管理体系的建立提供参考,对拟申请ISO 15189认可的医学实验室具有一定的指导意义和实用价值,可作为医学实验室规范化管理和标准化操作的实用性工具书和参考书。采访/晔问仁医 编辑/陈庆
版权声明:
本文系原创,未经授权不得转载。如需转载,请在[晔问仁医]后台留言;
授权使用请注明:“来源[晔问仁医]及作者”。
所有文章版权属于【晔问仁医】。
部分图片来源于网络,侵删。

